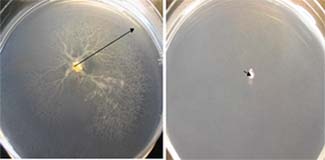
Motilitat en medi sòlid

- Home
Articles


New serological techniques for detecting antibodies against porcine circovirus
The Animal Health Research Centre (CRESA), with the collaboration of the INIA Biotechnology Department, has developed two new ELISAs for detecting antibodies against porcine circovirus, the etiological agent responsible several pig...

Human altruism is also a question of genetics
Given the importance of cooperation at the heart of human communities, science has looked for ways of turning it into a constant quality. According to many scientists, starting with Darwin and William Hamilton to the more recent theories of Edward Wilson and David Wilson, the...

Australia, pioneer in using prescribed burning
This research reveals Australia's technical excellence in forest management based on the practice known as prescribed burning. A tool already known to the aborigines of the area (albeit for other purposes), it consists of burning a specific area of natural land to rid it of...

Hepatozoon sp. detected in a feline colony in Barcelona
A research carried out by the Department of Animal Health and Anatomy at UAB's Faculty of Veterinary Medicine with the support of the Public Health Service of the Provincial Council of Barcelona


Invasive garden ants tells us that more will come
What can explain the great success of this and other invasive ants? It is known that social insects (bees, ants, wasps and termites) live in colonies in which all members cooperate in the work. Natural conditions in the various colonies compete for the same resources and...

- 1
- 2
- 3
- 4
- 5
- 6
- 7
- 8
- 9
- 10
- 11
- 12
- 13
- 14
- 15
- 16
- 17
- 18
- 19
- 20
- 21
- 22
- 23
- 24
- 25
- 26
- 27
- 28
- 29
- 30
- 31
- 32
- 33
- 34
- 35
- 36
- 37
- 38
- 39
- 40
- 41
- 42
- 43
- 44
- 45
- 46
- 47
- 48
- 49
- 50
- 51
- 52
- 53
- 54
- 55
- 56
- 57
- 58
- 59
- 60
- 61
- 62
- 63
- 64
- 65
- 66
- 67
- 68
- 69
- 70
- 71
- 72
- 73
- 74
- 75
- 76
- 77
- 78
- 79
- 80
- 81
- 82
- 83
- 84
- 85
- 86
- 87
- 88
- 89
- 90
- 91
- 92
- 93
- 94
- 95
- 96
- 97
- 98
- 99
- 100
- 101
- 102
- 103
- 104
- 105
- 106
- 107
- 108
- 109
- 110
- 111
- 112
- 113
- 114
- 115
- 116
- 117
- 118
- 119
- 120
- 121
- 122
- 123
- 124
- 125
- 126
- 127
- 128
- 129
- 130
- 131
- 132
- 133
- 134
- 135
- 136
- 137
- 138
- 139
- 140
- 141
- 142
- 143
- 144
- 145
- 146
- 147
- 148
- 149
- 150
- 151
- 152
- 153
- 154
- 155
- 156
- 157
- 158
- 159
- 160
- 161
- 162
- 163
- 164
- 165
- 166
- 167
- 168
- 169
- 170
- 171
- 172
- 173
- 174
- 175
- 176
- 177
- 178
- 179
- 180
- 181
- 182
- 183
- 184
- 185
- 186
- 187
- 188
- 189
- 190
- 191
- 192
- 193
- 194
- 195
- 196
- 197
- 198
- 199
- 200
- 201
- 202
- 203
- 204
- 205
- 206
- 207
- 208
- 209
- 210
- 211

